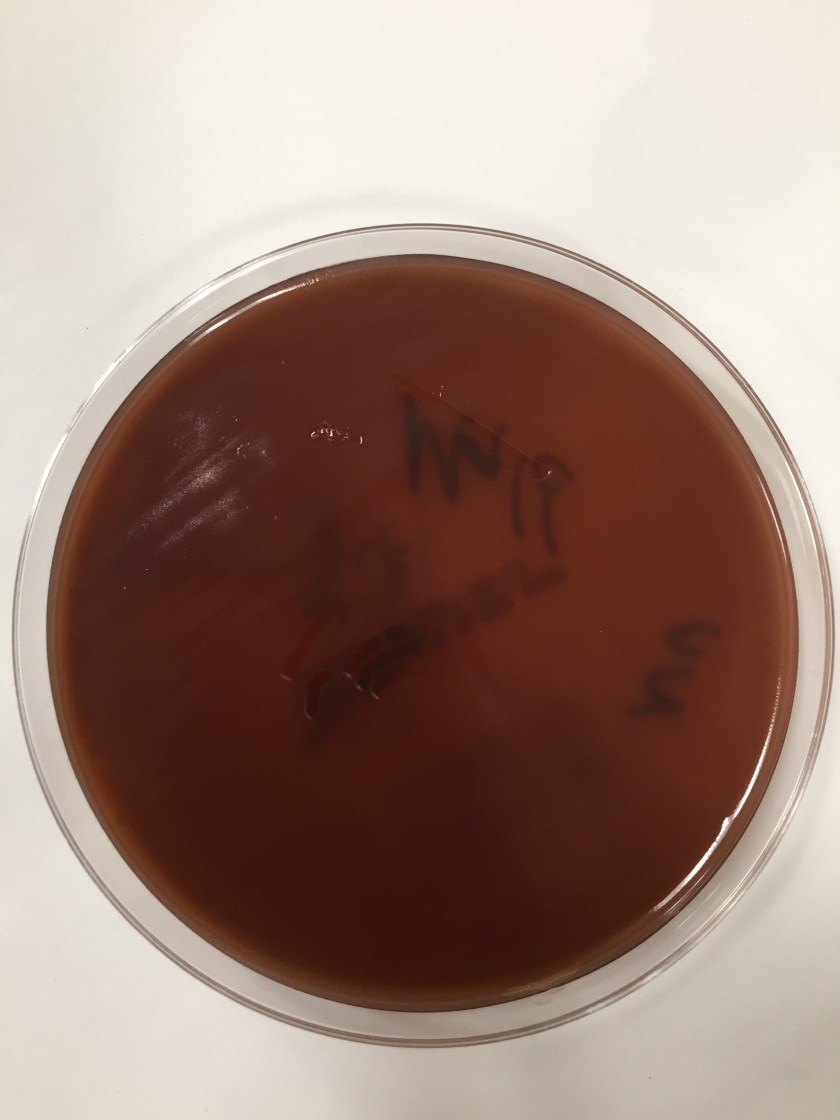
closept2

Case History
A 51 year old female with a past medical history for migraines was otherwise healthy up until 6 weeks ago when she began to notice progressive weakness, myalgia and new onset spontaneous lower extremity bleeding. She was evaluated by the internal medicine service and was found to be profoundly thrombocytopenic. A further workup consisting of a bone marrow biopsy revealed findings that were consistent with high-grade (Burkitt’s) lymphoma. She was initiated on chemotherapy. Two days after initiating chemotherapy she became profoundly pancytopenic with recurrent fevers. Additionally, she had worsening erythema and pain in her right buttocks and left thigh. Despite the usage of broad-spectrum antibiotics, her symptoms worsened. Two sets of blood cultures were drawn and the anaerobic bottles of both sets flagged positive after 15 hours.
Lab Identification
Gram stain revealed gram positive rods, some of which did not retain the crystal violet stain but all appeared box car shaped. This organism only grew under anaerobic conditions. On the anaerobic blood plate, the organism swarmed the media.

By use of mass spectrometry, the MALDI-TOF positively identified the organism as Clostridium septicum.
Discussion
Clostridium septicum is a gram positive, highly motile, spore-forming organism that grows best under anaerobic conditions. It is found ubiquitously in soil and at a low prevalence rate in the human gastrointestinal tract. C. septicum is best known for its ability to cause neutropenic enterocolitis and “atraumatic” (spontaneous) gas gangrene which is in contrast to “traumatic” gas gangrene caused by C. perfrigens .2 Both neutropenic enterocolitis and atraumatic gas gangrene are commonly seen in association with a malignancy usually hematologic or gastrointestinal in nature. Neutropenic entercolitis is mostly commonly seen in patients that are undergoing chemotherapy treatment. A combination of mucosal injury by the cytotoxic drugs, profound neutropenia, and impaired host defense allows for edema and necrosis of the bowel wall by microorganisms.1 This then allows for hematogenous dissemination of gut flora which includes C. septicum to more distal sites. It is also possible to have weakness in the mucosal lining from mass effect alone without any preceding neutropenia also allowing for hematogenous dissemination. In animal models C. septicum has been shown to be much more virulent than C. perfrigens requiring 300x fewer organisms to have the same lethal effect.2 This lethal infection even with appropriate treatment has a mortality rate of 60%.3
To diagnose C. septicum a gram smear will show gram positive rods with occasional rare sub terminal or terminal spores. They can often appear pleomorphic. They grow under anaerobic conditions and may start out as a single solid colony but usually swarm the plate after 24 hours growth. A more conclusive diagnosis can be made on the MALDI-TOF using mass spectrometry. Effective treatment requires both debridement of infected sites and appropriate antibiotics. The Infectious Diseases Society of America (IDSA) guidelines for skin and soft tissue infections recommend the use of high dose IV penicillin and IV clindamycin.4 Clindamycin is a protein synthesis inhibitor and is believed to aid in preventing toxin synthesis.
References:
- Urbach DR, & Rotstein, OD. Typhlitis. Cancer J Surg 1999; 42(6):3 415-419.
- Srivastava I, Aldape MJ, Bryant AE, Stevens DL, Spontaneous C. septicum gas gangrene: A literature review, Anaerobe (2017).
- Larson CM, Bubrick MP, Jacobs DM, West MA. Malignancy, mortality, and medicosurgical management of Clostridium septicum infection. Surgery. 118(4):592–597
- Stevens DL, Bisno AL, Chambers HF, et al. Executive Summary: Practice Guidelines for the Diagnosis and Management of Skin and Soft Tissue Infections: 2014 Update by the Infectious Diseases Society of America. Clinical Infectious Diseases 2014; 59:147–159.
-Noman Javed, MD is a 1st year anatomic and clinical pathology resident at the University of Vermont Medical Center.

-Christi Wojewoda, MD, is the Director of Clinical Microbiology at the University of Vermont Medical Center and an Associate Professor at the University of Vermont.
How did the patient fare?
We received a bone culture from her humerous that grew Clostridium septicum last month, which was 5 months after her first presentation. She is still receiving chemotherapy for her underlying lymphoma.
so will you reccomend prophylactic antibiotic cover for people undergoing chemotherapy?